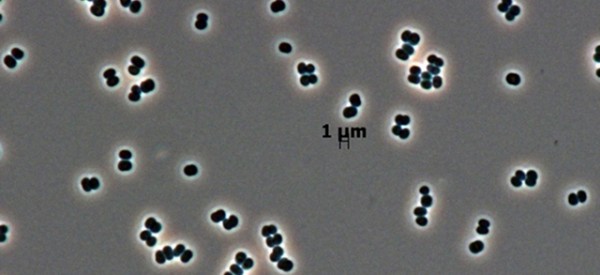

Gut Bacteria May Be Implicated in Rheumatoid Arthritis – Wired Science
rthritis is via Gut Bacteria May Be Implicated in Rheumatoid Arthritis – Wired Science.

rthritis is via Gut Bacteria May Be Implicated in Rheumatoid Arthritis – Wired Science.
Rare New Microbe Found in Two Distant Clean Rooms – NASA Jet Propulsion Laboratory.

Volume of nuclear waste could be reduced by 90 per cent says new research – News releases – News – The University of Sheffield.